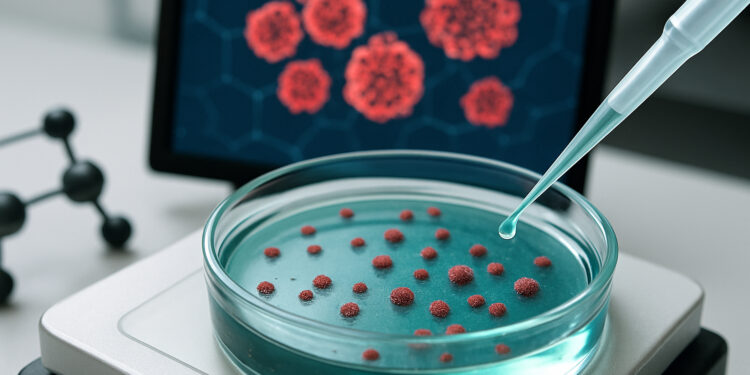
How Nanomedicine Is Redefining Drug Delivery Systems

Nanomedicine is transforming the future of healthcare by reshaping the way drugs are delivered, absorbed, and used within the body. Traditional treatments often struggle with challenges like poor absorption, harmful side effects, or imprecise targeting. Nanotechnology is changing this landscape by enabling medications to reach specific cells and tissues with unprecedented accuracy. As research advances, nanomedicine is emerging as one of the most promising innovations in modern therapeutics—bringing safer, smarter, and more effective drug delivery systems to patients worldwide.
Targeted Delivery for Better Outcomes
One of the most significant breakthroughs in nanomedicine is its ability to deliver drugs directly to diseased cells. Unlike conventional treatments that circulate broadly throughout the body, nanoparticles can be engineered to recognize specific biological markers. This allows them to travel precisely to cancer cells, infected tissues, or inflamed areas. Targeted delivery reduces exposure to healthy cells, minimizing side effects while maximizing therapeutic impact. This precision is particularly beneficial for conditions like cancer, where traditional treatments can be harsh on the body.
Improved Absorption and Controlled Release
Another advantage of nanomedicine is its ability to enhance drug absorption. Many medications break down too quickly or fail to reach adequate levels in the bloodstream. Nanoparticles protect the active ingredients and help them pass through biological barriers more efficiently. Some nanocarriers are designed for controlled release, slowly dispersing medication over time. This reduces the need for frequent dosing and helps maintain stable drug levels, improving both convenience and effectiveness for patients managing chronic conditions.
Overcoming Biological Barriers
The human body has several natural defenses that make drug delivery challenging—such as the blood-brain barrier or digestive enzymes. Nanotechnology enables medications to bypass or penetrate these barriers more successfully. For example, certain nanoparticles can carry drugs into the brain to treat neurological disorders that were previously difficult to address. This capability opens the door to new treatments for conditions like Alzheimer’s, Parkinson’s, and various brain cancers.
Fewer Side Effects and Greater Safety
By improving precision and stability, nanomedicine significantly reduces unwanted side effects. Patients receiving nanoparticle-based therapies often experience fewer complications, which enhances quality of life and increases treatment adherence. These safer profiles make nanomedicine a strong candidate for expanding use across different medical fields—from oncology and immunology to infectious disease and regenerative medicine.
Conclusion
Nanomedicine is redefining drug delivery by making treatments smarter, safer, and more efficient. Targeted delivery, enhanced absorption, and the ability to overcome biological barriers are transforming how medications work inside the body. As research continues, nanomedicine promises breakthroughs that will shape the next generation of medical therapies—bringing innovative solutions to patients who need them most.